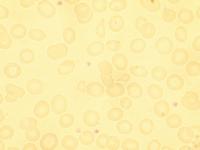

|
|
ß-Thalassaemia minor, Blutausstrich
Autor/en: F.-G. Hagmann
Institution/en: Westpfalz-Klinikum, Kaiserslautern
Serie zuletzt geändert am: 26.10.2011
Die Thalassaemia minor ist die heterozygote Form der beta-Thalassaemie.
Der erste Blutausstrich (Abb. 1-9) stammt von einem Kind mit bekannter Diagnose, das aus anderen Gründen stationär behandelt wurde. Die Laborwerte für das rote Blutbild sind charakteristisch: Hb 10, 6 d/dl, MCH 18 pg, MCV 55 fl. Demgegenüber sind die Erythrozytenveränderungen eher uncharakteristisch und vieldeutig.
Auch im zweiten Ausstrich (Abb. 10-13) herrschen Anisozytose, Anisochromasie, Poikilozytose und Anulozyten vor, man findet auch Target-Zellen, die zum Teil untypisch sind. Bei hypochromen mikrozytären Anämien, die sich klinisch und laborchemisch nicht eindeutig darstellen, sollte man an eine Thalassämie (im weitesten Sinn an eine Hämoglobinopathie) denken und eine entsprechende Diagnostik (Hämoglobinelektrophorese, ggf. molekularbiologische Verfahren) durchführen. Dies gilt auch, wenn der Name des Patienten "deutsch" ist. Durch Zuwanderung ist die Anzahl von Trägern dieses Gendefektes in Deutschland gestiegen. Sowohl der Name als auch die Erythrozytenmorphologie müssen die Diagnose einer T. minor nicht ohne weiteres vermuten lassen.
In der hämatologischen und der klinischen Symptomatik sind alle Abstufungen möglich! Im Gegensatz zur Eisenmangelanämie sind bei der Thalassämie das Serumeisen und -ferritin nicht vermindert. Zur Unterscheidung gibt es Formeln für die Erythrozytenindizes. HbA2 und HbF sind erst ab einem Lebensalter von 10-12 Monaten aussagekräftig, weshalb für die pränatale und Säuglingsdiagnostik molekularbiologische Verfahren eingesetzt werden. Bei einem weiteren Fall von T. minor sind schon in der Übersicht die Target-Zellen wegweisend (Abb. 14-17). Auch basophil punktierte und polychromatische Erythrozyten finden sich vermehrt.
Literaturreferenzen:
-
Kohne E. Hemoglobinopathies: clinical manifestations, diagnosis, and
treatment. Dtsch Arztebl Int 2011, 108(31-32). 532-40.
[Online]
-
Kohne E, Kleihauer E. Hämoglobinopathien - eine Langzeitstudie über vier Jahrzehnte. Dtsch Arztebl Int 2010;107:65-71
[Online]
-
Huber KR, et al. Molekularbiologische Diagnose von Thalassämien. Lab med 1994;18:326-332
-
Hehlmann R. Die Thalassämien - Klinik und genetische Basis. Dt Ärztebl 1980;77:2841-2848
-
Kapf CT, Jandl JH. Le sang - atlas commenté d’hématologie. Médecine et Sciences Internationales, Paris 1982
-
Hann IM, et al. Colour atlas of paediatric haematology. Second Edition. Oxford University Press 1990
|

 Zum Seitenanfang Zum Seitenanfang
 Sitemap
| Sitemap
|  |
| 
|
Anämie und Polyglobulie Der Hämatologische Notfall. Sysmex Kalender 2008 [ Mehr] Der Hämatologische Notfall. Sysmex Kalender 2008 [ Mehr] |
|